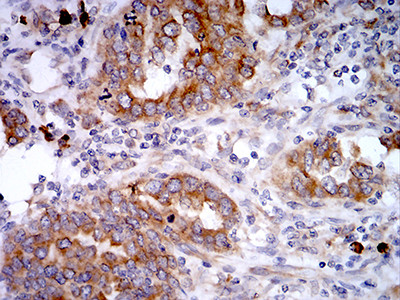
SELS Antibody in Immunohistochemistry (Paraffin) (IHC (P))

Search
Invitrogen
SELS Monoclonal Antibody (7F8G1)
{{$productOrderCtrl.translations['antibody.pdp.commerceCard.promotion.promotions']}}
{{$productOrderCtrl.translations['antibody.pdp.commerceCard.promotion.viewpromo']}}
{{$productOrderCtrl.translations['antibody.pdp.commerceCard.promotion.promocode']}}: {{promo.promoCode}} {{promo.promoTitle}} {{promo.promoDescription}}. {{$productOrderCtrl.translations['antibody.pdp.commerceCard.promotion.learnmore']}}
产品信息
MA5-31950
种属反应
已发表种属
宿主/亚型
分类
类型
克隆号
抗原
偶联物
形式
浓度
规格
纯化类型
保存液
内含物
保存条件
运输条件
RRID
产品详细信息
MA5-31950 has been tested in indirect ELISA.
靶标信息
This gene encodes a transmembrane protein that is localized in the endoplasmic reticulum (ER). It is involved in the degradation process of misfolded proteins in the ER, and may also have a role in inflammation control. It participates in the transfer of misfolded proteins from the ER to the cytosol, where they are destroyed by the proteasome in a ubiquitin-dependent manner. This protein is a selenoprotein, containing the rare amino acid selenocysteine (Sec). Sec is encoded by the UGA codon, which normally signals translation termination. The 3' UTRs of selenoprotein mRNAs contain a conserved stem-loop structure, designated the Sec insertion sequence (SECIS) element, that is necessary for the recognition of UGA as a Sec codon, rather than as a stop signal.
仅用于科研。不用于诊断过程。未经明确授权不得转售。
生物信息学
蛋白别名: ER membrane protein; MGC104346; MGC2553; protein x 0008; Selenoprotein S; SelS; tanis; valosin-containing protein-interacting membrane protein; VCP interacting membrane selenoprotein; VCP-interacting membrane protein
基因别名: AD-015; ADO15; SBBI8; SELENOS; SELS; SEPS1; VIMP
UniProt ID: (Human) Q9BQE4
Entrez Gene ID: (Human) 55829